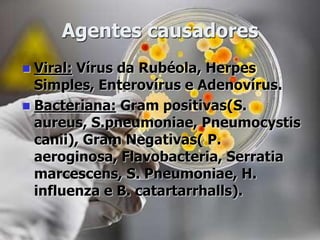
Agentes causadores
 Viral: Vírus da Rubéola, Herpes
Simples, Enterovírus e Adenovírus.
 Bacteriana: Gram positivas(S.
aureus, S.pneumoniae, Pneumocystis
canii), Gram Negativas( P.
aeroginosa, Flavobacteria, Serratia
marcescens, S. Pneumoniae, H.
influenza e B. catartarrhalls).

Este documento discute pneumonia em recém-nascidos, incluindo definição, etiologia, sinais e sintomas, diagnóstico, tratamento e prevenção. É apresentado um caso clínico de um recém-nascido de 9 dias internado com pneumonia e os respectivos diagnósticos e cuidados de enfermagem.